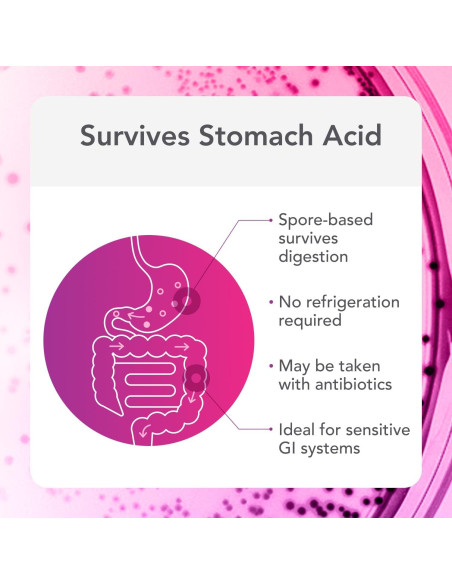
Biocidin Proflora 4R Probioticos Esporulados 30 Capsulas Veganas

Carrito
No hay más artículos en su carrito
Características destacadas
- Probióticos Esporulados Investigados Clínicamente - Presenta una mezcla potente de tres probióticos de Bacillus para la salud digestiva. Estas especies pueden ayudar a promover la absorción de nutrientes y el equilibrio microbiano en el intestino. Con nuestra formulación mejorada, hemos aumentado la potencia en un 33% a 4 mil millones de UFC.*
- Promover el Equilibrio y la Comodidad Digestiva - Diseñamos estos probióticos para mujeres y hombres que desean mantener una barrera intestinal saludable y apoyar la diversidad microbiana en el tracto gastrointestinal. También pueden ayudar a manejar la hinchazón ocasional, los gases y la indigestión mientras promueven la regularidad y los movimientos intestinales normales.*
- Con Botánicos Calmantes - Este suplemento probiótico diario combina probióticos formadores de esporas basados en suelo con Raíz de Malvavisco, Aloe Vera y Quercetina para ayudar a calmar el revestimiento intestinal.*
- Estable en Estante - Estas cápsulas probióticas para mujeres y hombres no requieren refrigeración y pueden sobrevivir a través del tracto gastrointestinal.
- Combinar con Biocidin o GI Detox Binder - Un gran probiótico esporulado independiente, y una adición perfecta a los protocolos de desintoxicación GI y limpieza intestinal de Biocidin. Probióticos para hombres y mujeres con ingredientes de grado profesional.*
Especificaciones técnicas
- Fabricante: Bio-Botanical Research
- Está descontinuado por el fabricante: No
- Peso: 0.2 kg
- Dimensiones: Ancho: 9 cm, Alto: 4.8 cm, Profundidad: 4.5 cm